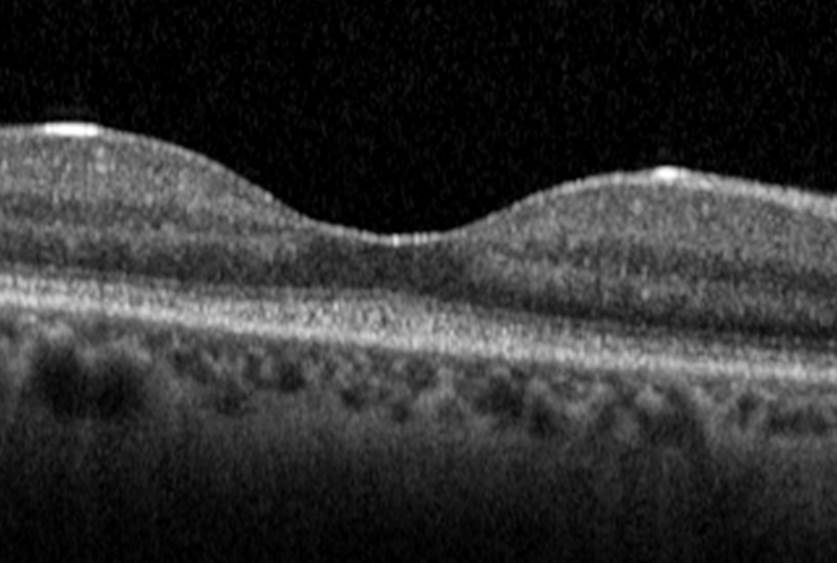

Optische Kohärenz-Tomographie (OCT)
Die Netzhaut, der lichtempfindliche Film des Auges, besteht aus zahlreichen Schichten, die unterschiedliche Funktionen haben. Erkrankungen des Augenhintergrundes gehen meist mit einer Strukturveränderung einer oder auch mehrerer dieser Schichten der Netzhaut insbesondere im Bereich der Makula einher.
Die einzelnen Schichten der Netzhaut können vom Augenarzt mit dem Augenspiegel alleine nicht erkannt werden, sondern nur mit einer hochauflösenden optischen Computertomographie, die keine Röntgen-Strahlen sondern niedrig energetisches Laserlicht zur Bildgewinnung verwendet. Dieses Verfahren nennt man optische Kohärenz Tomographie (OCT).
Das Gerät erlaubt durch die hohe Bildauflösung eine exzellente und frühzeitige Darstellung feinster Veränderungen der Netzhautschichten und ist damit das wichtigste und am häufigsten durchgeführte Verfahren zur Diagnostik von Erkrankungen des Augenhintergrundes.
Durch die digitale Bildspeicherung und -verarbeitung ist die optische Kohärenz-Tomographie aber auch ein hervorragendes Instrument zur Verlaufsbeobachtung von Netzhauterkrankungen. So kann zum Beispiel bei einem Patienten mit feuchter Makuladegeneration das Ansprechen auf die Therapie schon 24 Stunden nach Beginn der Therapie im OCT-Bild nachgewiesen werden.

Normale Makula eines jungen Mannes in der Schnittbildaufnahme mit dem OCT. Die einzelnen Schichten der Netzhaut sind gut erkennbar.
Die Makula eines gleichalten jungen Mannes mit juveniler Makuladegeneration und deutlich reduzierter Sehschärfe. Die Netzhaut ist zentral verdünnt und die einzelnen Netzhautschichten sind im Vergleich zum obigen Bild kaum noch zu erkennen.
